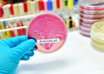

Deep forehead wrinkles may signal a higher risk for cardiovascular mortality
ESC 2018 Press Release | Aug 27, 2018
Too much of a good thing? Very high levels of “good” cholesterol may be harmful
ESC 2018 Press Release | Aug 27, 2018
Non-invasive eye test may offer early Alzheimer's diagnosis: JAMA
IANS | Aug 25, 2018
No safe level of alcohol; adverse health risks outweigh supposed benefit: Lancet
IANS | Aug 25, 2018
E.coli could aid in fight against anaemia
IANS | Aug 25, 2018
Indians lose over 1.5 years of their lives to air pollution: Study
PTI | Aug 25, 2018
E-cigarette users at higher risk of heart attack
ANI | Aug 24, 2018
Maternal depression may affect child’s immune and psychological health
ANI | Aug 24, 2018
Insominia, sleep medication: Use and abuse
ANI | Aug 24, 2018
Air pollution triggers cardiovascular disease, finds study
ANI | Aug 24, 2018
Most read this week